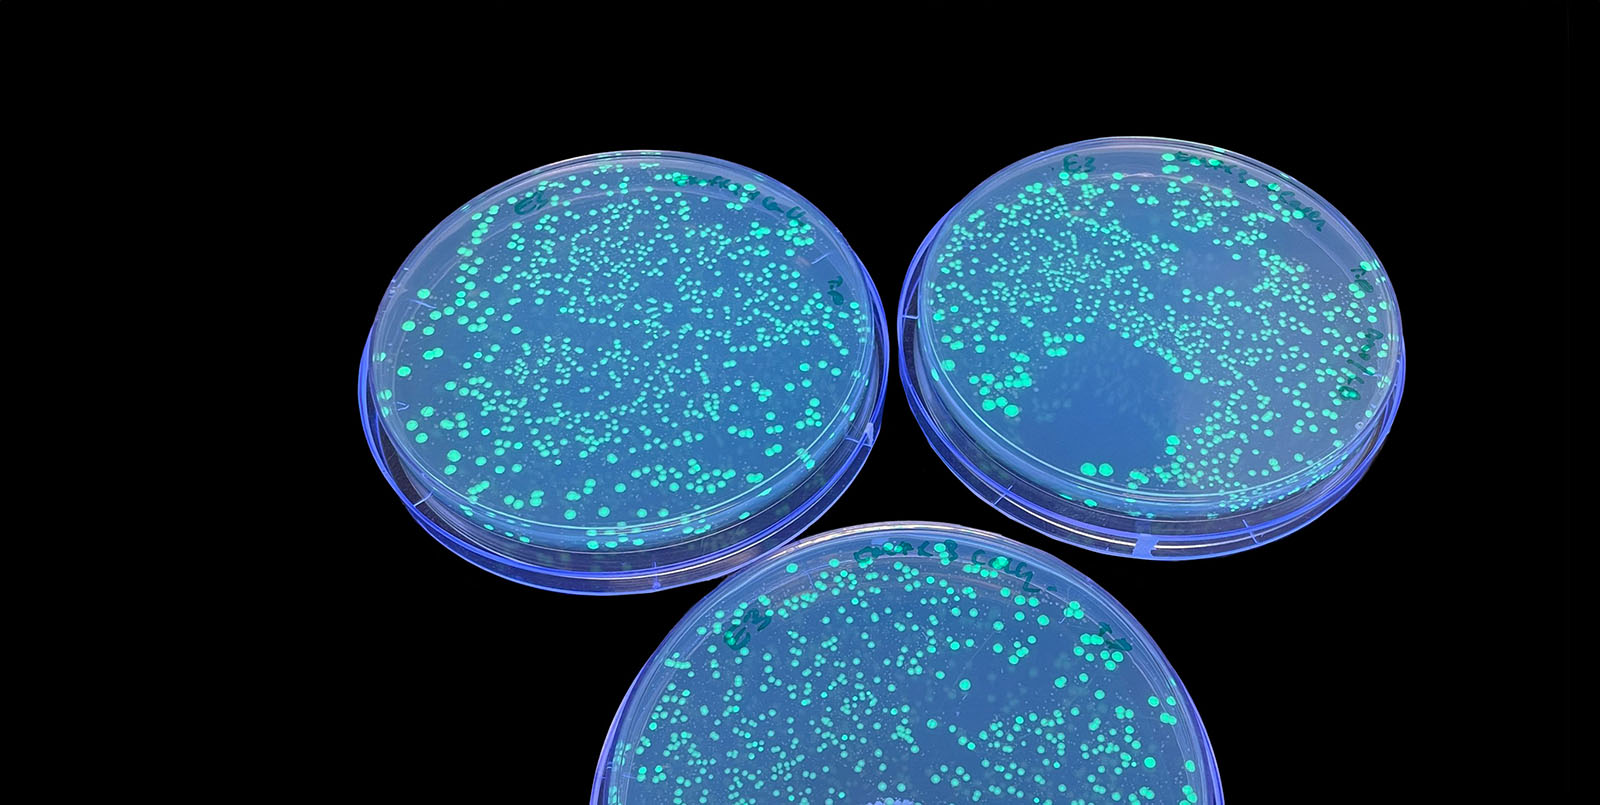

Aussie invention predicts power line faults that can cause bushfires
An early fault detection (EFD) system designed at RMIT University is helping to prevent bushfires and blackouts in North America, Europe and Australia.
Radio waves can tune up bacteria to become life-saving medicines
Scientists from Australia and the United States have found a new way to alter the DNA of bacterial cells – a process used to make many vital medicines including insulin – much more efficiently than standard industry techniques.
A promising leap towards computers with light-speed capabilities
Scientists have created a reprogrammable light-based processor, a world-first, that they say could usher in a new era of quantum computing and communication.
RMIT experiment on-board Swedish rocket launch
A new type of electromagnetic shield designed and manufactured at RMIT will be launched into space next week.